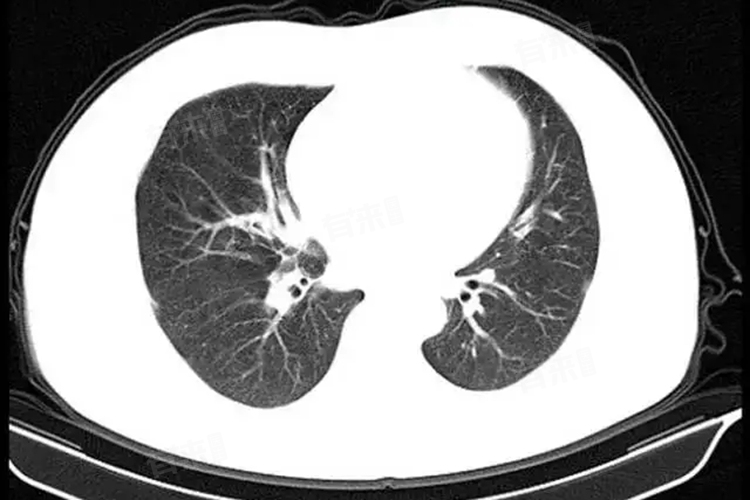

肺部CT可以在一定程度上看出肋骨的异常,但对于肋骨的病变,如肋骨骨折、肋骨肿瘤、肋骨骨质疏松等,其诊断价值比较有限。如果怀疑肋骨存在异常,建议及时到医院就诊,在医生建议下进行针对性检查和治疗。
- 肺部CT是一种影像学检查方法,通过使用X射线和计算机技术,能够生成高分辨率的肺部图像。这些图像不仅展示了肺部的结构、形态和病变情况,同时也能够显示肋骨的形态和位置。在肺部CT检查中,如果肋骨存在明显的形态改变或位置异常,如肋骨骨折后的错位、肋骨肿瘤的占位等,这些异常是可以在图像上被观察到的。
- 虽然肺部CT可以显示肋骨的形态和位置,但对于肋骨骨折的诊断,尤其是隐匿性骨折或轻微骨折,其诊断价值相对有限。因为CT主要是环形平扫,有可能骨折平面扫不到或者漏诊。此时,肋骨的三维CT可能更为准确,能够将肋骨进行360°重建,从而发现隐匿的骨折并排除多根多段的肋骨骨折。
- 虽然肺部CT可以筛查出肋骨肿瘤,但对于肿瘤的具体性质、大小、范围以及是否侵犯周围组织等信息的判断,可能需要结合其他检查手段,如活检穿刺等。
肺部CT在评估肋骨骨质疏松方面也有一定的局限性。虽然低剂量肺CT结合定量CT可以用于骨质疏松的筛查,但这种方法主要用于评估骨密度,而对于肋骨骨质疏松的具体诊断,还需要结合患者的临床症状、骨密度检查结果以及其他影像学检查进行综合判断。

